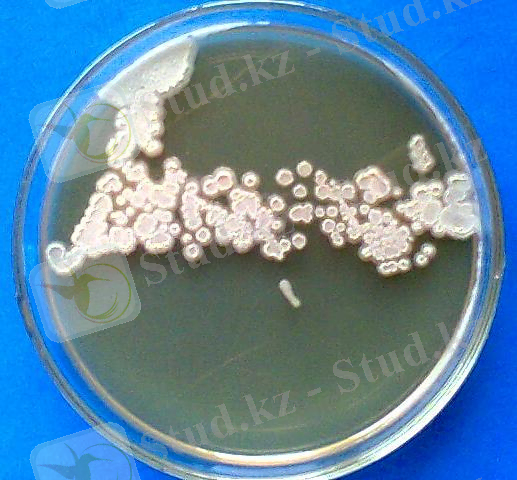

ТАН сериялы сүт қышқыл сусындарының микрофлорасының морфо-биохимиялық сипаттамасы


ӘЛ - ФАРАБИ АТЫНДАҒЫ ҚАЗАҚ ҰЛТТЫҚ УНИВЕРСИТЕТІ
Биология факультеті
Микробиология кафедрасы
БІТІРУ ЖҰМЫСЫ
«ТАН» СЕРИЯСЫ СУСЫНДАРЫНЫҢ МИКРОФЛОРАСЫНА МОРФО-БИОХИМИЯЛЫҚ СИПАТТАМА БЕРУ
Орындаған: Қасымбекова С. С.
4 курс студенті
Ғылыми жетекшісі:
б. ғ. к. Баубекова А. С.
“ ” 2008 ж
Нормобақылаушы Ибраймова М. Ж.
“ ” 2008 ж
Қорғауға жіберілді
кафедра меңгерушісі, Жұбанова A. A.
б. ғ. д., профессор
“ ” 2008 ж.
Алматы, 2008
РЕФЕРАТ
Бітіру жұмысы 38 беттен, 16 суреттен, 6 кестеден тұрады, 48 әдебиет пайдаланылған.
Кілтті сөздер: сүт қышқыл бактериялары, физиологиялық активтілік, емдік - диетикалық, пробиотикалық, активті қышқыл, активті штамм, «ТАН», «ARTEZIAN ТАН», «Алтын ТАҢ», MRS.
Қысқарған сөздер: Lb. - Lactobacillus
Leuc. - Leuconostoc
Lac. - Lactococcus
ЕПЖ - ет-пептонды желатин
ГСА - гидролизденген сүтті агар
МС - майсыздандырылған сүт
Қазіргі таңда экологиялық ахуалдың нашарлауына байланысты туындайтын індеттер саны артып барады. Ондай індеттердің алдын алу үшін пробиотикалық қасиеті жоғары препараттар мен емдік әртүрлі сүт қышқыл сусындарын ойлап табуда. Солардың ішінде жоғары сұранысқа ие, аралас ашу процесінің өнімі - «ТАН» сүт қышқыл сусындары болып табылады. Олардың құрамына сүт қышқылын активті түзетін және антагонистік қасиеті жоғары сүт қышқыл таяқшалары кіреді. Сондықтан бұндай өнімдер адам микроэкологиясын жақсартып, иммунитетін көтеріп, денін сауықтырады. Сондай-ақ, өкпе және асқазан ауруларының алдын алу үшін өте тиімді. Практикалық маңызды (активті қышқыл түзушілер, антагонистік қасиеті жоғарылар, антибиотик түзушілер т. б. ) штамдарды бөліп алып, солардың негізінде жаңа емдік - диетикалық сусындарды алу арқылы жоғарыда аталған аурулардың алдын алуға және орташа өмір сүру уақытының көрсеткішін арттыруға болады.
Жұмыстың мақсаты: «ТАН» сериясы сусындарының микрофлорасына морфо-биохимиялық сипаттама беру.
Жұмыстың міндеттері:
- «ТАН» сериясы сусындарының микрофлорасын зерттеу.
- Бөлініп алынған сүт қышқыл бактерияларының морфолого-культуралдық және физиолого-биохимиялық қасиеттерін анықтау.
- Бөлініп алынған сүт қышқыл бактерияларының практикалық маңызды қасиеттерін анықтау.
МАЗМҰНЫ
КІРІСПЕ
Сүт қышқыл бактериялары ерте кезден бері адам баласының күнделікті тұрмысында қолданылып келеді. Сүт қышқыл бактериялары нан пісіру, балық тұздау, көкөністерді консервілеу, сүт қышқылды және десерттік шырындар мен өнімдерді дайындау, мал азығын сүрлеу, тері және былғары өндеу сияқты жеңіл және тағам өнеркәсіптерінде кеңінен қолданылады. Микробиологияның дамуына байланысты сүт қышқыл бактерияларының морфологиялық, физиологиялық және культуралдық қасиеттері туралы білімдер толықтырылып, олардың қолдану сферасы да әлдеқайда кеңейді.
Қазіргі таңда сүт қышқыл бактерияларының көмегімен емдік және диетикалық қасиеттерге ие жаңа сүт қышқыл өнімдері өндірілуде [1] . Солардың ішінде жоғары сұранысқа ие, аралас ашу процесінің өнімі - «ТАН» сүт қышқыл сусындары болып табылады. Олардың құрамына сүт қышқылын активті түзетін және антагонистік қасиеті жоғары сүт қышқыл бактериялары мен сүт қанты - лактозаны ыдыратып, спирттік ашу процесін жүзеге асыратын ашытқылар кіреді. Сондықтан бұндай өнімдер адам микроэкологиясын жақсартып, иммунитетін көтеріп, денін сауықтырады. Сондай-ақ, өкпе және асқазан ауруларының алдын алу үшін өте тиімді болып келеді.
Осыған байланысты, «ТАН» сериясының сүт қышқыл сусындарының микрофлорасын зерттеу, олардың физиолого-биохимиялық қасиеттерін анықтау арқылы олардың ішінен ең активтілерін бөліп алу аса маңызды болып отыр.
1 ӘДЕБИЕТКЕ ШОЛУ
1. 1 Сүт қышқыл бактерияларының жалпы сипаттамасы
Ерте заманда-ақ адам баласы сүтқышқыл өнімдерін өндірген. Бірақ, адам сүттің ашуы мен ұйюына бір тылсым күш әсер етеді деп ойлаған.
Қазіргі кезде сүттің ашуы да, ұйюы да сүт қышқыл бактерияларының қатысуымен жүретіні анықталды. Сонымен қатар сүт қышқыл бактерияларын төрт туысқа жіктейді. Бірақ олар әр түрлі тұқымдасқа және жоғары токсономиялық деңгейге жатады [2] .
Берджи ( Bergey S Manual et Systematic Bacteriology 1997 ) анықтағаны бойынша Lactococcus, Pediococcus, Leuconostoc Lactococcaceae тұқымдасы грам оң бактерияларға жатқызылады, ал Lactobacillus туысын Lactobacilliaceae тұқымдасының грам оң аспорогенді таяқша тәрізді бактериялары деп бөледі [3] . Жүйелегенде өзгергіштік ауқымын ескеруге тырысады және көптеген қасиеттері мен құрамын зерттеу негізінде түрлерін ажыратып, жіктейді [4] .
Сүт қышқыл бактерияларын жеке топқа жіктеуге мүмкіндік беретін негізгі қасиеттері - олардың ашу процессінің негізінде соңғы және негізгі өнім ретінде сүт қышқылын түзуі. Олар сүт қышқылын қанттарды ашыту арқылы түзеді. Ашыту процесі барысында сүт қышқылынан басқа сірке қышқылы, янтарь қышқылы, спирт және көмірқышқыл газы (СО2) түзіледі. Кейбір сүт қышқыл бактериялары тек сүт қышқылын ғана бөлсе, басқалары аталған қосымша өнімдерді де түзеді екен. Осыған байланысты сүтқышқыл бактерияларын үлкен 2 топқа жіктейді: гомоферментативтілер және . Гомоферментативті ашу процесі барысында бір молекула қанттан (глюкоза, лактоза т. б. ) екі молекула сүт қышқылы түзіледі. Бүл процесті Lactococcaceae тұқымдасының өкілдері - Pediococcus және Lac. lactis , таяқшалардан Lactobacilliaceae тұқымдасының Lb. lactis және Lb. bulgaris сияқты өкілдері жүзеге асырады. Ал гетероферментативті ашу процесінде қанттың бір молекуласынан бір молекула сүт қышқылы, этанол және СО2 түзіледі. Процесті Leuconostoc туысының өкілдері мен Lactobacilliaceae тұқымдасының Lb. mesenteroides және Lb. dextranicum тағы басқа сол сияқты өкілдері жүргізеді. Бұдан басқа бифидобактериумды ашу процесі белгілі. Бұнда ашу негізінде бір молекула қанттан үш молекула сірке қышқылы және екі молекула сүт қышқылы түзіледі. Процесс бифидобактериялар көмегімен жүреді. Сүт қышқыл бактерияларынан басқа бұл өнімді (сүт қышқылын) көптеген басқа бактериялар да түзеді. Бірақ, олар тек қосымша, аралық өнім ретінде өте аз мөлшерде ғана түзеді [5] .
Жүйелегенде сүт қышқыл бактерияларының төмендегідей қасиеттеріне назар аударылады: клетка морфологиясы (таяқшалар, кокктар немесе сопақ), клеткалардың өзара орналасуы (жеке-жеке немесе тізбектеле), Грам бойынша олар оң боялуы керек, спора түзбейді, қозғалмайды (дегенмен, таксономиялық мәнін ескеруге болады, яғни қозғалатын және спора түзетін сүт қышқыл бактерияларының да кездесетіні жөнінде өте сирек мағлұматтар бар), факультативті анаэробтар, әдетте каталаза түзбейді. Сонымен қатар жеке түрлердің белгілі бір көмірсуларды ашытуы, қоректік ортаның кейбір факторларын (амин қышқылдарын, витаминдердің түрлерін) қажет етуі, ашытудың соңғы өнімі - сүт қышқылының оптикалық айналымы, серологиялық қасиеті, оптималды өсу температурасы да сүт қышқыл бактерияларын түрге дейін жіктеудің негізі бола алады [4, 5] .
Сүт қышқыл бактерияларының клеткалық пішіні әр түрлі: сопақша, дөңгелек және таяқша тәрізді болады. Пішіні дөңгелек және сопақша тәрізді клеткалардың өлшемі 0, 5 -1, 0 х 0, 8-1, 0 мкм, ал таяқша тәізділер 0, 5-0, 8 х 2, 0-9, 0 мкм аралығында болады. Клеткалары жеке, қосарланып, шоғырланып, қысқа және ұзын тізбектер түзіп орналасады [6] .
Даму кезінде бактериялардың морфологиясы өзгеріске ұшырауы мүмкін. Мысалы, сүт қышқыл лактококктар алғашқы кезеңінде ұзын тізбекті таяқша тәрізді элементтерден тұрады, ал кейін кокк тәрізді пішінге айналады. Алайда сүт қышқыл бактериялары белгілі бір факторлардың әсерінен де морфологиясын, тіпті физиолого-биохимиялиқ қасиеттерін де өзгерте алатыны белгілі [7] . Мысалы, құрамында В 12 витамині бар қалыпты ортада Lb. leichmanii өзіне тән пішінге ие болады да, ал В 12 витамині жоқ немесе оның бір аналогтарымен алмастырылған қоректік ортада ол жіп тәрізді пішінге көшетіні анықталған. Сүт қышқыл бактерияларының көптеген өкілдерінің морфологиясы ортадағы пептонның мөлшеріне де байланысты өзгеруі мүмкін. Айталық, ортада пептонның мөлшері аз болған жағдайда, олар өте ұсақ жеке-жеке орналасқан таяқшалар түрінде болса, ал ортада пептон мөлшері жеткілікті болған жағдайда, тізбектелген, ірі, тіпті ұзын таяқшаларға айналатындығы белгілі [8] .
Сондай-ақ, сүт қышқыл бактерияларының пішіндерінің ұзаруы оларды рН=3, 7 болғандағы немесе 6% NaCl қосылғандағы қоректік ортада дақылдағанда байқалады. Рентген сәулесі мен этил спирті де сүт қышқыл бактерияларына осылай әсер етеді. Себебі, рентген сәулесі мен этил спирті клетканың өсуін емес бөлінуін тежейді. Нәтижесінде бөлінбеген, ұзарып өскен, ұзын клеткалар қалыптасады [7, 8] .
Қатты қоректік ортада 1 мм әрі ұсақ нүкте тәрізді колониялар түрінде өседі. Колония пішіні домалақ немесе дұрыс емес (бұрыс) пішінді, ақ немесе ақшыл түсті (ескірген колониялар сарғыш болуы мүмкін), колония шеті тегіс немесе аздап шашыраңқы, профилі томпақ болып келеді [8, 9] .
Дегенмен колония сипаттамасы да әрқашан бірдей бола бермейді. Көптеген зерттеушілер сүт қышқыл бактериялар 2 типті колониялар түзеді деген тұжырым жасайды [5, 8] . Біріншісі, S-типті, яғни домалақ, өте ұсақ, шеті де, беті де тегіс, профилі томпақ, мөлдір және жылтыр колониялар (сурет 1) . Бұндай типті колонияларды әдетте өте қысқа, қозғалмайтын таяқшалар немесе моншақ тәрізді (стрептоккок) тізбектелген кокктар түзеді. Бұл бактерияларды физиологиялық ерітіндіге салатын болсақ, ол біркелкі лайланады. Екіншісі, R-типті, яғни кедір-бұдыр, S-типінен салыстырмалы түрде ірі (2-3 мм дейін), сұрғылт немесе көкшіл ақ түсті, жылтыр емес, колония шеті біршама шашыранқы болып келеді (сурет 2) . Қоректік ортаға тығыз жабысып өседі. Бұндай колонияларды кейде тізбектелген ұзын таяқшалар, кейде тізбектелген қысқа таяқшалар түзеді. Физиологиялық ерітіндіде біркелкі лайланбайды, яғни физиологиялық активтілігі S-типке қарағанда төмен.
Көптеген жеке ғалымдардың зерттеулері көрсеткендей S-типті колониялар түзетін сүт қышқыл бактериялар R-типті колониялар түзетіндеріне қарағанда жоғары активтілік көрсетеді. Мысалы, Tracy R. L. атты ғалым өзінің 1938 жылғы жүргізген жұмыстарында
Lb. plantarum
S-типті колония түзетін штамы глюкозадан, арабинозадан, рафинозадан қышқыл түзетін, активті штамм екенін, ал дәл осы
Lb. plantarum
R-типті колония түзетін штамы глюкозадан қышқыл түзбейтін, активтілігі төмен штамм екенін анықтаған [9] .
Көптеген жеке ғалымдардың зерттеулері көрсеткендей S-типті колониялар түзетін сүт қышқыл бактериялар R-типті колониялар түзетіндеріне қарағанда жоғары активтілік көрсетеді. Мысалы, Tracy R. L. атты ғалым өзінің 1938 жылғы жүргізген жұмыстарында
Lb. plantarum
S-типті колония түзетін штамы глюкозадан, арабинозадан, рафинозадан қышқыл түзетін, активті штамм екенін, ал дәл осы
Lb. plantarum
R-типті колония түзетін штамы глюкозадан қышқыл түзбейтін, активтілігі төмен штамм екенін анықтаған [9] .
Аталған 2 типті колониялардын басқа ароматтүзуші сүт қышқыл бактерияларда О-типті колония байқалған. Бұндай колониялар S-типті колонияға сипаттамасы бойынша өте жақын. Бірақ, бұндай колониялар шырышты болып келеді.
 S-типті колония қоректік ортаның құрамына байланысты R-типке көшіп отыратындығын Полладина О. К. (1941 ж. ) байқаған. Ол колониялардың бір типтен екінші типке көшуі О → S → R сызбанұсқасы бойынша жүреді, яғни «сатылы эволюция» нәтижесінде өзгеріп отырады деген. Бұндай бір типтен екінші типке аусулар қоректік орта жағдайлары мен құрамына тікелей байланысты. Егер қоректік орта белоктарға бай болса (негізінен пептон болған жағдайда), онда R-типті колониялар түзіледі [10] .
S-типті колония қоректік ортаның құрамына байланысты R-типке көшіп отыратындығын Полладина О. К. (1941 ж. ) байқаған. Ол колониялардың бір типтен екінші типке көшуі О → S → R сызбанұсқасы бойынша жүреді, яғни «сатылы эволюция» нәтижесінде өзгеріп отырады деген. Бұндай бір типтен екінші типке аусулар қоректік орта жағдайлары мен құрамына тікелей байланысты. Егер қоректік орта белоктарға бай болса (негізінен пептон болған жағдайда), онда R-типті колониялар түзіледі [10] .
Сүт қышқыл бактериялары нитраттан нитритті тотықтырмайды, пигмент түзбейді. Көмісуды ашыту нәтижесінде өсуі үшін оттексіз орта қажет, яғни анаэробты жағдайда өседі. Дегенмен, көпшілігіне оттегі аз әсер ететіндіктен оттекті ортада да өсе береді. Бұл жағдайда оттегі акцепторы ретінде флавопротеин қатысады, бірақ АТФ пайда болмайды. Тіпті оттегі қатысқан жағдайда АТФ синтезі субстрат деңгейінде фосфорлану арқылы жүзеге асады, яғни ашу процесі аэробты тыныс алуға ауыспайды. Осыған байланысты сүт қышқыл бактериялары аэротолерантты анаэробтарға жатады. Сүт қышқыл бактериялары ортаның рН 5, 5-9, 0 дейінгі аралығында, кейбіреулері рН 3, 0-3, 2 аралығындағы кышқылды ортада да өсе береді. Көптеген штамдар үшін оптималды өсу рН деңгейі 6, 8-7, 2 тең келеді [11] .
Температура әсеріне байланысты сүт қышқыл бактериялары мезофилді және термофилді болып бөлінеді. Мезофилділер үшін қолайлы температура 20-30°С аралығында, ал термофилділер үшін 40-50°С немесе одан да жоғары болуы мүмкін [12, 13] .
Сүт қышқыл бактерияларының өздеріне тән негізгі ерекшеліктері этил спиртіне төзімділіктері. Кейбір түрлері құрамында 15-18 % об. этил спирті бар ортада өсе береді. Қоректенуіне байланысты сүт қышқыл бактерияларының гетеротрофты түрлері қарапайым синтетикалық қоректік ортада өспейді. Энергия көзімен бірге амин қышқылдарын, витаминдерді, пурин және пиримидинді қажет етеді. Витаминдер өздерінің түрлеріне байланысты клеткада маңызды қызмет атқарады. Сүт қышқыл бактерияларының витаминдерді қажет етуі қоректік ортада белгілі бір амин қышқылдарының, май қышқылының және де дезоксирибозиттердің болу-болмауына байланысты. Қоректік орта құрамында өсімдік қайнатпасының және ашытқы автолизатының болуы, сүт қышқыл бактерияларының витаминді қажет етуін қанағаттандырады. Сүт қышқыл бактериялардының өсуі үшін тағы да басқа органикалық факторлардың яғни, нуклеин, май қышқылының және кейбір амин қышқылы туындыларының маңызы зор. Олардың біреуі өсу факторы болса, ал кейбіреуі стимулятор, яғни тездеткіш қызметін атқарады. Кейбір дақылдар тимидинсіз өспейді. Белок гидролизаты, лимон, сірке, олеин, линолен, линол қышқылдары сүт қышқыл бактерияларының өсуін тездетеді. Сүт қышқыл бактерияларының дамуына марганец, натрий, калий, фосфор, темір және басқа да органикалық емес қосылыстар керек. Бұл қосылыстардың көпшілігі қызанақ, орамжапырақ сөлінде және басқа да табиғи субстраттарда кездеседі. Лабораториялық жағдайларда дақылдау үшін қолданылатын қоректік орталар бактериялардың барлық қажеттіліктерін және физиолого-биохимиялық ерекшеліктерін ескере отырып жасалады. Сондай қоректік орталарға MRS, гидролизденген сүтті агар, майсыздандырылған сүт, ашытқы экстракты және сәбіз бен орамжапырақ қайнатпалары жатады [14] . Қазіргі кезде кең қолданылатын қоректік орталардың бірі - MRS (MRS-1, MRS-2, MRS-3, MRS-4, MRS-5) және М-21. Бұл қоректік орталар құрамының негізі ашытқы экстракты, пептон, твин-80, тұздар және қант көзі (глюкоза немесе лактоза) болып табылады, яғни сүт қышқыл бактерияларының өсуіне қажетті барлық амин қышқылдары мен витаминдер және макро-, микроэлементтер кіреді. Құрамы қоректік заттар мен қосымша факторларға бай болғандықтан, бұл қоректік орта басқа да көптеген микроорганизмдерге қолайлы болып табылады. Сондықтан сүт қышқыл бактерияларымен жұмыс істенген кезде аса стерильділікті сақтау керек [15] .
Сүт қышқыл бактериялары субстрат ретінде триглицеридті пайдалана отырып, липолитикалық активтілікке ие болады. Хош иісті қоспаларының пайда болуы осы сүт қышқыл бактерияларына байланысты болады. Сүт қышқыл бактерияларының хош иісті түзу қасиетіне деген қызығушылық оларды май, сыр өндірісінде қолдануға негіз болған. Хош иіс түзуі, оладың құрамындағы қоспалар диацетил, L-дикетон, 2, 3-бутадион, май қышқылының эфирі және кейбір альдегид пен кетондарға байланысты [16] .
Сүт қышқыл бактериялары негізінен карбонил қосылыстарын, яғни альдегид, диацетил, ацетоинды синтездейді. Ацетоин хош иісті затқа жатпайды, бірақ ацетилге ауыса алады [16. 17] . Хош иісті заттардың синтезі қоректік орта құрамына және штамның ерекшеліктеріне байланысты болады. Қоректік ортаның құрамына глюкоза, лимон қышқылы және оның тұздарын қосу хош иісті заттардың пайда болуына мүмкіндік жасайтындығы өте ерте кездегі зерттеулерден белгілі болды. Көмірсудың жалғыз көзі ретінде глюкозасы бар қоректік ортада тек қана сүт қышқылы немесе сірке қышқылы жинақталса, ал глюкоза мен лимон қышқылы бар ортада ацетоин мен диацетил өндіріледі. Сондықтан, лимон қышқылын кальций қосындысымен гидролиздеп, олардан хош иіс түзуші штамдарын бөліп алады [18] . Хош иіс түзушілерге: Lac. diacetylactis, Leuc. cremoris, Leuc. dextranicum сияқты сүт және сүт өнімдері микрофлорасына кіретін сүт қышқыл бактериялары жатады. Хош иісті заттардың түзілуіне температура, тотығу-тотықсыздану потенциалы, ортаның рН дәрежеші әсер етеді. Мысалы: сүт қышқыл лактококктарының хош иісті қосылыстарды түзуінің оптималды жағдайы температура 23-25°С, рН деңгейі 5, 0-ке тең, тотығу-тотықсыздану потенциалы Eh 6 болып, ұйытқыны оттегімен байыту үшін белсенді араластырып отырған жағдайда туындайды [19] .
1. 2 Сүт қышқыл бактерияларының таралуы
Сүт қышқыл бактериялары табиғатта кеңінен таралған. Олар тек сүт және сүт өнімдерінде ғана емес, сонымен қатар, өсімдіктердің эпифитті микрофлорасының құрамына кіріп, өсімдіктердің тамыры мен топырақта, адам мен жануарлардың ас қорыту - ішек жолдары мен сілемейлі қабаттарында және т. б. кездеседі [20] .
Cүт қышқыл бактерияларының кең таралған табиғи субстраты - cүт және сүт өнімдері. Онда сүт қышқыл бактерияларының көптеген түрлері кездеседі [21] . Олардың тіршілік әрекеттерінің негізінде әр түрлі қосылыстар түзіліп, сүт қышқыл өнімдерді қалыптастырады. Үй жағдайында сүтке арнайы жағдайлар (бетін жауып жылы орап қою, сүзгіш дорбаларға құйып қою, арнайы ұйытқыларды қос т. б. ) жасай отырып айран, қатық, ірімшік сияқты сүт өнімдерін алды. Ұйытқы ретінде бастапқыда сәтті алынған айранның үлгісін қолданылады. Белгілі ережелер мен стандарттар болмағандықтан, әр кез сайын алынған айранның қасиеттері өзгеріп отыруы мүмкін. Ал өндірісте өндірілетін сүт қышқыл өнімдерінің микрофлорасы өндірістік қолайлы, активті штамдардан тұрады. Мысалы: айран және қымыз өндірісінде Lac. lactis, Lb. buchneri, Lb. brevis, Lb. bulgaricum, Lb. acidophilum, сірке қышқыл бактериялары, ашытқылар - Saccharomyces lactis және Torulopsis туысының өкілдерін ұйытқы дайындауда қолданады. Қатық, қаймақ, сары май өндірістерінде ұйытқы негізінен Lac. lactis, Leuc. cremoris, Lac. cremoris, Lac. diacetylactis, Leuc. dextranicum сияқты сүт қышқыл бактерияларынан дайындалынады. Ал Мечников айраны, Оңтүстік айран, ТАН сияқты қышқылдылығы жоғары сусындардың құрамынан термофильді сүт қышқыл бактерияларын кездестіруге болады. Себебі бұндай сусындарды алу үшін Laс. thermophilus, Lb. bulgaricum, Lb. acidophilum, Lb. lactis, Lb. helveticum сияқты термофильді, активті сүт қышқыл бактерияларын қолданады. Сондай-ақ, сүт қышқыл бактерияларын әртүрлі ірімшіктердің құрамынан да кездестіруге болады. Ірімшік өндірісіндегі маңызды микрофлораға пропион қышқыл бактерияларымен қатар Lb. casei subsp. rhamnosus сүт қышқыл бактериясы да кіреді [22] .
Сүт қышқыл бактериялары құстардың, жылықанды жануарлардың әсіресе, сүтқоректілердің ас қорыту мүшелерінде үнемі өмір сүреді. Сондай-ақ, оларды адамның да ас қорыту жүйесінің кез келген жерінен табуға болады. Адамның ас қорыту - ішек жолдарында сүт қышқыл бактерияларының 40 астам түрлері кездеседі. Адамның ішек микроэкологиясын құрайтын негізгі бактериялар - лактобациллдер болып табылады. Лактобацилдердің Lb. acidophilum және Lb. bulgaricum түрлері басқа сүт қышқыл бактерияларына қарағанда ас қорыту - ішек жолдарында ұзақ тіршілік ете алады және сүт қышқылын активті түзуші, жоғары антагонистік қасиетке ие таяқшалар. Тіпті нәрестелік шақта да сәбилердің ас қорыту жүйесі жолдарынан бифидобактерияларды табуға болады [23, 24] .
Сүт қышқылы бактерияларының ең көп әртүрлілігі күйіс қайтаратын малдардың ас қорыту - ішек жолдарында кездеседі. Мысалы: бұзаулардың, қойлар мен бұқалардың асқазанынан Lb. acidophilum, Lb. plantarum Lb. fermentum, Lb. buchneri, Lac. bovis, сонымен қатар, Lb. bifidus (құстардың ішек жолдарынан оңай бөлініп алынады) түрлерін бөліп алуға болады [25] . Сондай-ақ, Lb. dextranicum, Lb. delbrukii, Lb. casei, Lb. brevis, Laс. lactis, Lac. cremoris, Lac. faecalis, Lac. liquefaciens т. б. термофильді түрлерін де сүтқоректілердің ас қорыту - ішек жолдарынан кездестіруге болады [24, 25, 26] .
... жалғасы- Іс жүргізу
- Автоматтандыру, Техника
- Алғашқы әскери дайындық
- Астрономия
- Ауыл шаруашылығы
- Банк ісі
- Бизнесті бағалау
- Биология
- Бухгалтерлік іс
- Валеология
- Ветеринария
- География
- Геология, Геофизика, Геодезия
- Дін
- Ет, сүт, шарап өнімдері
- Жалпы тарих
- Жер кадастрі, Жылжымайтын мүлік
- Журналистика
- Информатика
- Кеден ісі
- Маркетинг
- Математика, Геометрия
- Медицина
- Мемлекеттік басқару
- Менеджмент
- Мұнай, Газ
- Мұрағат ісі
- Мәдениеттану
- ОБЖ (Основы безопасности жизнедеятельности)
- Педагогика
- Полиграфия
- Психология
- Салық
- Саясаттану
- Сақтандыру
- Сертификаттау, стандарттау
- Социология, Демография
- Спорт
- Статистика
- Тілтану, Филология
- Тарихи тұлғалар
- Тау-кен ісі
- Транспорт
- Туризм
- Физика
- Философия
- Халықаралық қатынастар
- Химия
- Экология, Қоршаған ортаны қорғау
- Экономика
- Экономикалық география
- Электротехника
- Қазақстан тарихы
- Қаржы
- Құрылыс
- Құқық, Криминалистика
- Әдебиет
- Өнер, музыка
- Өнеркәсіп, Өндіріс
Қазақ тілінде жазылған рефераттар, курстық жұмыстар, дипломдық жұмыстар бойынша біздің қор #1 болып табылады.



Ақпарат
Қосымша
Email: info@stud.kz